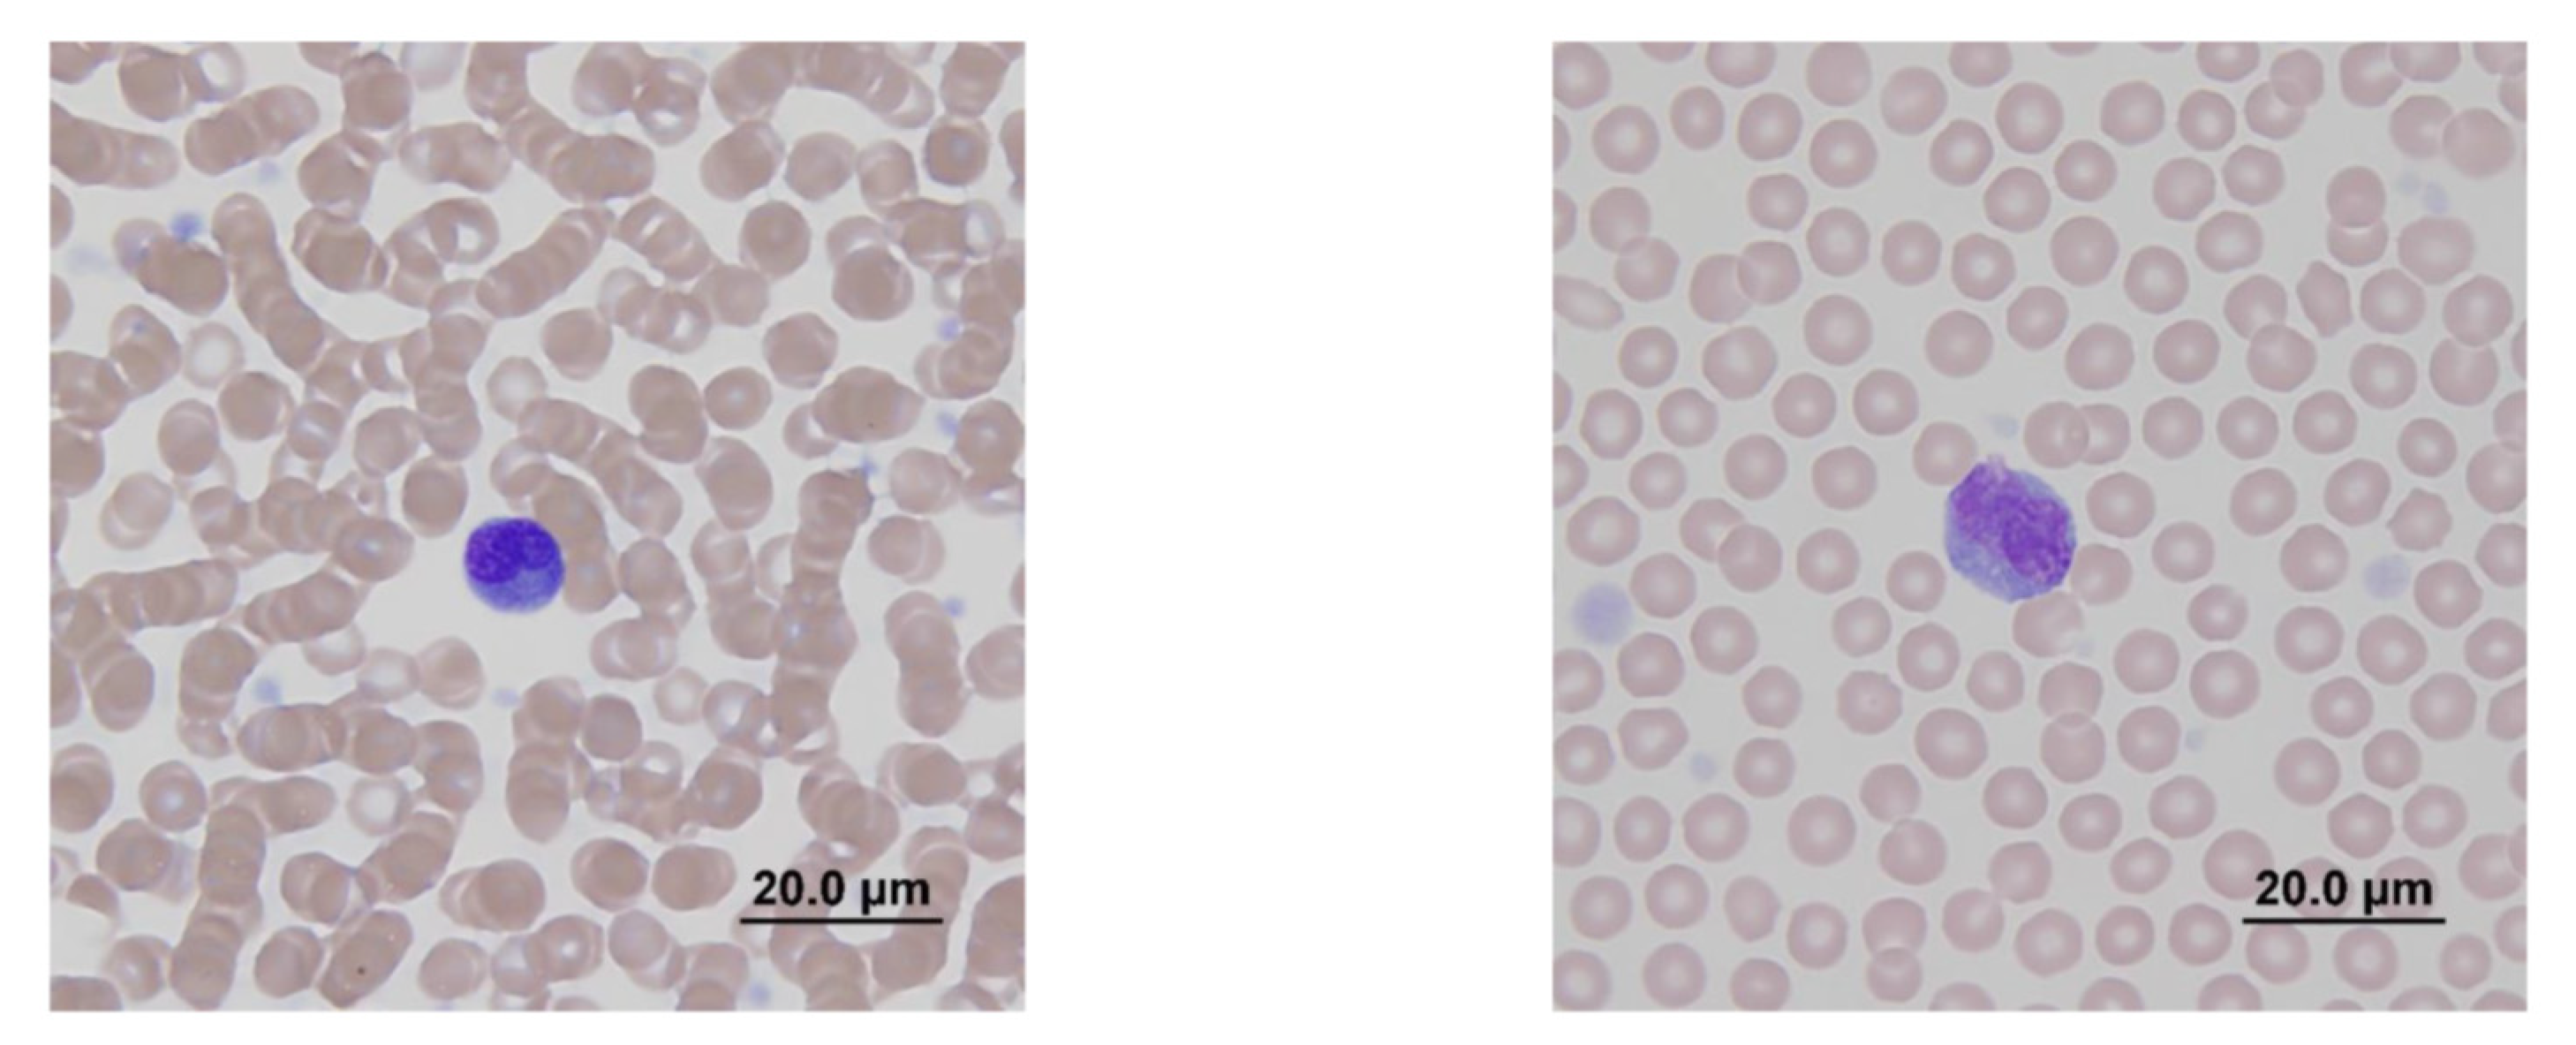
Molecules 25 03604 g002 Molecules 25 03604 g002

Safety Evaluation of an Alpha-Emitter Bismuth-213 Labeled Antibody to (1→3)-β-Glucan in Healthy Dogs as a Prelude for a Trial in Companion Dogs with Invasive Fungal Infections
Abstract
1. Introduction
2. Results
3. Discussion
4. Materials and Methods
4.1. Radionuclides, Radiolabeling, and Quality Control of the Radiolabeled Antibody
4.2. Administration of Radiolabeled Antibody to Dogs and Follow up Analyses
4.3. Radiation Safety for the Research and Veterinary Staff
5. Conclusions
Author Contributions
Funding
Conflicts of Interest
References
- Enoch, D.A.; Yang, H.; Aliyu, S.H.; Micallef, C. The Changing Epidemiology of Invasive Fungal Infections. Methods Mol. Biol. 2017, 1508, 17–65. [Google Scholar] [PubMed]
- Davies, J.L.; Epp, T.; Burgess, H.J. Prevalence and geographic distribution of canine and feline blastomycosis in the Canadian prairies. Can. Vet. J. 2013, 54, 753–760. [Google Scholar] [PubMed]
- Larson, S.M.; Carrasquillo, J.A.; Cheung, N.K.; Press, O.W. Radioimmunotherapy of human tumours. Nat. Rev. Cancer 2015, 15, 347–360. [Google Scholar] [CrossRef] [PubMed]
- Dadachova, E.; Nakouzi, A.; Bryan, R.A.; Casadevall, A. Ionizing radiation delivered by specific antibody is therapeutic against a fungal infection. Proc. Natl. Acad. Sci. USA 2003, 100, 10942–109427. [Google Scholar] [CrossRef] [PubMed]
- Helal, M.; Dadachova, E. Radioimmunotherapy as a Novel Approach in HIV, Bacterial, and Fungal Infectious Diseases. Cancer Biother. Radiopharm. 2018, 33, 330–335. [Google Scholar] [CrossRef] [PubMed]
- Nosanchuk, J.D.; Dadachova, E. Radioimmunotherapy of fungal diseases: The therapeutic potential of cytocidal radiation delivered by antibody targeting fungal cell surface antigens. Front. Microbiol. 2012, 12, 283. [Google Scholar] [CrossRef] [PubMed]
- Bryan, R.A.; Guimaraes, A.J.; Hopcraft, S.; Jiang, Z.; Bonilla, K.; Morgenstern, A.; Bruchertseifer, F.; Del Poeta, M.; Torosantucci, A.; Cassone, A.; et al. Toward developing a universal treatment for fungal disease using radioimmunotherapy targeting common fungal antigens. Mycopathologia 2011, 173, 463–471. [Google Scholar] [CrossRef] [PubMed]
- Helal, M.; Allen, K.J.H.; van Dijk, B.; Nosanchuk, J.D.; Snead, E.; Dadachova, E. Radioimmunotherapy of blastomycosis in a mouse model with a (1→3)-β-glucans targeting antibody. Front. Microbiol 2020, 11, 147. [Google Scholar] [CrossRef] [PubMed]
- Gray, N.A.; Baddour, L.M. Cutaneous inoculation blastomycosis. Clin. Infect. Dis. 2002, 34, 44–49. [Google Scholar] [CrossRef] [PubMed]
- McDonald, R.; Dufort, E.; Jackson, B.R.; Tobin, E.H.; Newman, A.; Benedict, K.; Blog, D. Notes from the field: Blastomycosis cases occurring outside of regions with known endemicity-New York, 2007–2017. MMWR Morb. Mortal Wkly. Rep. 2018, 67, 1077–1078. [Google Scholar] [CrossRef] [PubMed]
- Bethge, W.A.; Wilbur, D.S.; Storb, R.; Hamlin, D.K.; Santos, E.B.; Brechbiel, M.W.; Fisher, D.R.; Sandmaier, B.M. Selective T-cell ablation with bismuth-213-labeled anti-TCRalphabeta as nonmyeloablative conditioning for allogeneic canine marrow transplantation. Blood 2003, 101, 5068–5075. [Google Scholar] [CrossRef] [PubMed]
- Bethge, W.A.; Wilbur, D.S.; Sandmaier, B.M. Radioimmunotherapy as non-myeloablative conditioning for allogeneic marrow transplantation. Leuk Lymphoma 2006, 47, 1205–1214. [Google Scholar] [CrossRef] [PubMed]
- Allen, K.J.H.; Jiao, R.; Malo, M.E.; Frank, C.; Dadachova, E. Biodistribution of a radiolabeled antibody in mice as an approach to evaluating antibody pharmacokinetics. Pharmaceutics 2018, 10, 262. [Google Scholar] [CrossRef] [PubMed]
- Allen, K.J.H.; Jiao, R.; Malo, M.E.; Frank, C.; Fisher, D.R.; Rickles, D.; Dadachova, E. Comparative radioimmunotherapy of experimental melanoma with novel humanized antibody to melanin labeled with 213Bismuth and 177Lutetium. Pharmaceutics 2019, 11, 348. [Google Scholar] [CrossRef]
Sample Availability: Samples of the compounds are not available from the authors. |

© 2020 by the authors. Licensee MDPI, Basel, Switzerland. This article is an open access article distributed under the terms and conditions of the Creative Commons Attribution (CC BY) license (http://creativecommons.org/licenses/by/4.0/).
Share and Cite
Helal, M.; Allen, K.J.H.; Burgess, H.; Jiao, R.; Malo, M.E.; Hutcheson, M.; Dadachova, E.; Snead, E. Safety Evaluation of an Alpha-Emitter Bismuth-213 Labeled Antibody to (1→3)-β-Glucan in Healthy Dogs as a Prelude for a Trial in Companion Dogs with Invasive Fungal Infections. Molecules 2020, 25, 3604. https://doi.org/10.3390/molecules25163604
Helal M, Allen KJH, Burgess H, Jiao R, Malo ME, Hutcheson M, Dadachova E, Snead E. Safety Evaluation of an Alpha-Emitter Bismuth-213 Labeled Antibody to (1→3)-β-Glucan in Healthy Dogs as a Prelude for a Trial in Companion Dogs with Invasive Fungal Infections. Molecules. 2020; 25(16):3604. https://doi.org/10.3390/molecules25163604
Chicago/Turabian StyleHelal, Muath, Kevin J. H. Allen, Hilary Burgess, Rubin Jiao, Mackenzie E. Malo, Matthew Hutcheson, Ekaterina Dadachova, and Elisabeth Snead. 2020. "Safety Evaluation of an Alpha-Emitter Bismuth-213 Labeled Antibody to (1→3)-β-Glucan in Healthy Dogs as a Prelude for a Trial in Companion Dogs with Invasive Fungal Infections" Molecules 25, no. 16: 3604. https://doi.org/10.3390/molecules25163604
APA StyleHelal, M., Allen, K. J. H., Burgess, H., Jiao, R., Malo, M. E., Hutcheson, M., Dadachova, E., & Snead, E. (2020). Safety Evaluation of an Alpha-Emitter Bismuth-213 Labeled Antibody to (1→3)-β-Glucan in Healthy Dogs as a Prelude for a Trial in Companion Dogs with Invasive Fungal Infections. Molecules, 25(16), 3604. https://doi.org/10.3390/molecules25163604

